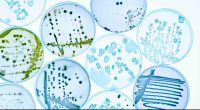
Microbiological cultures

HMC Capital (ASX:HMC) has paid $950 million to pick up France-based renewables giant Neoen’s Victorian assets. Neoen has become, through its continued investment in Australian renewables assets, one of the country’s largest such developers, with irons in fires in a majority of states down under.
As for HMC, it wants the assets so that it can then “seed [its] energy transition platform,” bringing total assets under management (AUM) to $19B billion.
In Victoria, Neoen has 10 assets – four operational, six in development, with a total generation capacity of over 2,800MW. HMC says it was selected because it didn’t need to take Neoen through the foreign investment board.
“The acquisition of Neoen’s Victoria portfolio represents an extremely unique, event-driven opportunity to secure a high quality technologically diversified operating portfolio with a significant long-term development pipeline together with an accomplished development team,” HMC Capital head of energy transition Angela Karl said.
“This will cement our Top 10 position in renewable energy and storage in the National Energy Market from Day One and we look forward to working collaboratively with Neoen, our customers, our landowners and other key stakeholders to implement a smooth transition.”
One other name pops up on HMC’s energy transition team – that of its chair, former Australian Prime Minister Julia Gillard.
“We look forward to partnering with some of Australia’s leading institutional investors in creating a clean energy future and fighting against climate change,” Gillard said – unsurprising coming from the woman who introduced a carbon tax, the only measure that has ever meaningfully seen emissions go down in Australia.
HMC last traded at $12.19.
Join the discussion: See what HotCopper users are saying about HMC Capital and be part of the conversations that move the markets.
The material provided in this article is for information only and should not be treated as investment advice. Viewers are encouraged to conduct their own research and consult with a certified financial advisor before making any investment decisions. For full disclaimer information, please click here.